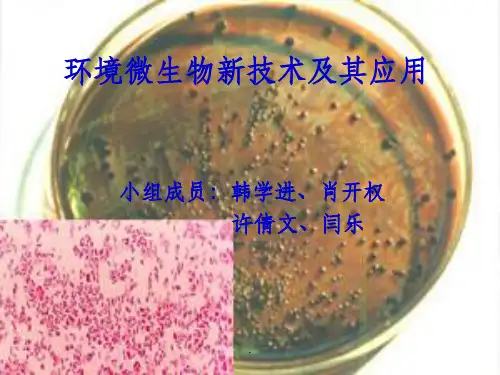

放线菌:小单孢菌、卡诺氏菌、链霉菌 等。
.
②.淀粉降解过程 在有氧条件下,一些酶将淀粉水解为葡
萄糖,然后进入三羧酸循环彻底降解为CO2 和H2O;在无氧条件下,经微生物的厌氧发 酵,其降解为小分子有机物(乙酸、丙酮、 丁醇、丁酸等)和无机物(CO2、H2)。
.
好氧分解
枯草芽孢杆菌
-淀粉酶
-淀粉酶
.
5.无论是厌氧生物处理还是好氧生物处理 MSW,都存在着各式各样的微生物种群, 正是这些微生物种群的相互协调,组成了 一个复杂的生态系统,从而去除了MSW的 有机成分,甚至转化成为了可再生利用的 资源。
.
二、利用微生物降解大分子有机污染物
大分子有机污染物可分为:多糖类、木 质素、脂类等。
多糖类有机污染物又可分为:纤维素、 淀粉、半纤维素等。这类污染物广泛存在 于动物尸体和植物残体及废料中。
.
1.微生物对纤维素的降解 ①.自然中存在的、工业生产中排放的废水、
城市生活垃圾中都存在着纤维素。 能分解纤维素的微生物有:细菌、放线菌和
真菌。 细菌:噬纤维菌属、纤维弧菌属、纤维单胞
菌属等。 放线菌:链霉菌、诺卡氏菌属、小单孢菌属。 真菌:青霉、曲霉、镰刀霉、根霉、木霉及
毛霉
.
②.降解过程 在有氧条件下,微生物用纤维素酶作
由于藻类对重金属离子具有较强的富集 能力,利用其生物吸附作用可从产业污水中 去除有毒、放射性金属和回收稀有、珍贵 金属。该法具有高效、经济、简便、选择 性好等优点,尤其适用于低浓度及一般方法 不易去除的金属。如用菌藻共生体从无营 养液的含As、As的废水中除砷率可达80% 以上,含营养液的As去除率>70%,As往除率 >50%;用啤酒酵母菌和盐泽螺旋藻对Cd、 Ni、Cu有明显吸收;用固定在聚砜基质上的 真菌可除往Cd、Cu、Pb、Ni;Pb的去除还 可用林可链霉素和黑根. 霉菌。